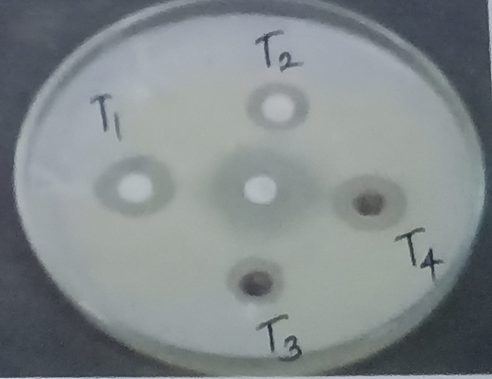

We use cookies to ensure our website works properly and to personalise your experience. Cookies policy

We use cookies to ensure our website works properly and to personalise your experience. Cookies policy
Department of Pharmaceutical Chemistry, Pallavan Pharmacy College, Kanchipuram
Microwave Assisted Synthesis (MWAS) technique which significantly lowers the chemical waste and reaction time. MWAS has been utilized to synthesize the 2,4,5-Triphenylimidazole by Debus-Radziszewski imidazole synthesis. From the literature survey, 2,4,5-Triphenylimidazole derivatives were synthesized under MWAS using Benzil, Ammonium Acetate and Aldehydes like Benzaldehyde, 4-chlorobenzaldehyde, 4-Nitrobenzaldehyde and 4-Methoxbenzaldehyde by Condensation reaction. Compounds were synthesized in the presence of Glacial acetic acid as a catalyst in solvent-free condition. The purity of the compound was determined by Thin Layer Chromatography (TLC). The synthesized compounds were screened using FT-IR. All synthesized compounds were evaluated and analogized for anti-mycotic activity.
1.1. Microwave Assisted Synthesis (MWAS):
Microwave Assisted Synthesis is an increasingly prominent technique in synthetic organic chemistry, known for its ability to shorten reaction times and enhance product yields through the use of microwave radiation. A significant benefit of this method is the reduction or elimination of organic solvent usage, making it more environmentally sustainable. Additionally, Microwave Assisted Synthesis offers greater convenience and ease of control compared to conventional methods.
1.1.1. General Considerations for Microwave Assisted Synthesis
Power : 100-1000 watts.
Frequency : 2.45 GHz.
Temperature : 50 to 300°C
Reaction time: A few seconds to several minutes
1.1.2. Principle of Microwave Assisted Synthesis
Microwave radiation penetrates the material, causing the molecules to oscillate, which in turn generates heat. This heat is rapidly distributed throughout the material at a distinctive rate and time, leading to a fast and highly efficient reaction.
1.1.3. Mechanism of Microwave Assisted Synthesis
The three primary mechanisms responsible for Microwave heating are:
(a) Dipolar polarization: For a substance to produce heat under Microwave irradiation, it must have a dipole, i.e. its molecular structure must have regions of partial positive and negative charges.
(b) Ionic conduction: In this process, charged particles, typically ions, dissolved in a medium, move back and forth due to the influence of Microwave radiation, generating heat.
(c) Interfacial polarization: This mechanism combines both dipolar polarization and ionic conduction, where heat is generated at the interface between different phases or materials, enhancing the overall heating effect.
1.2. Imidazole
Imidazole is a nitrogen-containing heterocyclic aromatic compound featuring a planar five-membered ring with two nitrogen atoms. The molecular structure, represented by the chemical formula (CH)?N(NH)CH, contributes to its versatile reactivity and biological significance. While imidazole is a synthetic compound, it has numerous naturally occurring derivatives. These derivatives exhibit a broad spectrum of pharmacological activities, including antifungal, antibacterial, antidepressant, anti-inflammatory, and antihypertensive properties, making them valuable in therapeutic and medicinal applications.
1.3. 2, 4, 5-Triphenylimidazole
The 2, 4, 5-Triphenylimidazole compound has gained significant attention due to its exploration potential and various pharmacological applications. It is characterized by the attachment of three phenyl groups at the 2nd, 4th, and 5th positions of the imidazole ring, a structural feature contributing to its unique properties and reactivity.

Figure 1 Structure of 2,4,5-Triphenylimidazole
2. Experimental Work
2.1. Preparation of 2,4,5-Triphenylimidazole
An equimolar mixture of Benzil (0.2mole), Benzaldehyde (0.02 mole) and Ammonium acetate (0.07mole) was placed in a Borosilicate beaker and thoroughly mixed using a glass rod. The reaction mixture was then subjected to Microwave irradiation for a total duration of 1–2 minutes. Upon completion of the irradiation process, the mixture was allowed to cool at room temperature before being quenched in ice water (70ml), followed by the addition of Ammonium hydroxide (6ml) to facilitate precipitation. The resulting solid product was collected by filtration using a Buchner funnel, washed with water and subsequently dried. Finally, the crude product was recrystallized from ethanol to obtain a purified compound suitable for further characterization.

2.2. Preparation of 2-(4-chlorophenyl)-4,5-diphenyl-1H-imidazole
An equimolar mixture of Benzil (0.2mole), 4-chlorobenzaldehyde (0.02 mole), and Ammonium acetate (0.07mole) was placed in a Borosilicate beaker and thoroughly mixed using a glass rod. The reaction mixture was then subjected to Microwave irradiation for a total duration of 1–2 minutes. Upon completion of the irradiation process, the mixture was allowed to cool at room temperature before being quenched in ice water (70ml), followed by the addition of Ammonium hydroxide (6ml) to facilitate precipitation. The resulting solid product was collected by filtration using a Buchner funnel, washed with water, and subsequently dried. Finally, the crude product was recrystallized from ethanol to obtain a purified compound suitable for further characterization.

2.3. Preparation of 2-(4-nitrophenyl)-4,5-diphenyl-1H-imidazole
An equimolar mixture of Benzil (0.2mole), 4-nitrobenzaldehyde (0.02 mole), and Ammonium acetate (0.07mole) was placed in a Borosilicate beaker and thoroughly mixed using a glass rod. The reaction mixture was then subjected to Microwave irradiation for a total duration of 1–2 minutes. Upon completion of the irradiation process, the mixture was allowed to cool at room temperature before being quenched in ice water (70ml), followed by the addition of Ammonium hydroxide (6ml) to facilitate precipitation. The resulting solid product was collected by filtration using a Buchner funnel, washed with water, and subsequently dried. Finally, the crude product was recrystallized from ethanol to obtain a purified compound suitable for further characterization.

2.4. Preparation of 2-(4-methoxyphenyl)-4,5-diphenyl-1H-imidazole
An equimolar mixture of Benzil (0.2mole), 4-methoxybenzaldehyde (0.02 mole), and Ammonium acetate (0.07mole) was placed in a Borosilicate beaker and thoroughly mixed using a glass rod. The reaction mixture was then subjected to Microwave irradiation for a total duration of 1–2 minutes. Upon completion of the irradiation process, the mixture was allowed to cool at room temperature before being quenched in ice water (70ml), followed by the addition of Ammonium hydroxide (6ml) to facilitate precipitation. The resulting solid product was collected by filtration using a Buchner funnel, washed with water, and subsequently dried. Finally, the crude product was recrystallized from ethanol to obtain a purified compound suitable for further characterization.

3. Characterisation
3.1. Thin Layer Chromatography
A technique for identifying the formation of new compounds and assessing their purity.The solvent system used was Methanol: Chloroform: Acetic acid glacial (7:2:1).The developed spots were detected by using an Iodine chamber.
The Rf values of the compounds were calculated using the formula,
Rf value = Distance travelled by the sample / Distance travelled by the solvent front.
3.2. Fourier Transform Infrared Spectroscopy
Infrared spectroscopy measures the interaction of infrared radiation with matter through absorption, emission, or reflection. It is utilized to analyze and identify the functional groups in synthesized compounds. The region to analyze is 4000- 400cm-1.
4. RESULT AND DISCUSSION
4.1. Physical Data
Table No.1
|
Name of the compounds |
Molecular formula |
Molecular weight |
Appearance |
% yield |
|
2,4,5-Triphenyl-1H-imidazole |
C21H16 N2 |
296.37g/mol |
Yellow |
77.3% |
|
2-(4-chlorophenyl)-4,5-diphenyl-1H-imidazole |
C21H15Cl N2 |
330.82g/mol |
Off-white |
82.80% |
|
2-(4-nitrophenyl)-4,5-diphenyl-1H-imidazole |
C21H15 N3O2 |
341.36g/mol |
Dark yellow |
92% |
|
2-(4-methoxyphenyl)-4,5-diphenyl-1H-imidazole |
C22H18 N2O |
326.4 g/mol |
Off-white |
72.64% |
Table No.2
|
Name Of the Compounds |
Rf Values |
|
2,4,5-Triphenyl-1H-imidazole |
0.86 |
|
2-(4-chlorophenyl)-4,5-diphenyl-1H-imidazole |
0.78 |
|
2-(4-nitrophenyl)-4,5-diphenyl-1H-imidazole |
0.72 |
|
2-(4-methoxyphenyl)-4,5-diphenyl-1H-imidazole |
0.66 |
4.3. Fourier Transform Infrared Spectroscopy

Figure 2 Structure of 2,4,5-Triphenyl-1H-imidazole

Figure 3 Structure of 2-(4-chlorophenyl)-4,5-diphenyl-1H-imidazole

Figure 4 Structure of 2-(4-nitrophenyl)-4,5-diphenyl-1H-imidazole

Figure 5 Structure of 2-(4-methoxyphenyl)-4,5-diphenyl-1H-imidazole
Table No.3
|
Name Of the Compounds |
Types Of Vibrations |
Observed Values (cm-1) |
|
2,4,5-Triphenyl-1H-imidazole |
1559.91 1211.20 1166.88 691.76 |
C=C (Stretching) C-N (Stretching) C-C (Stretching) Ar-CH (Bending) |
|
2-(4-chlorophenyl)-4,5-diphenyl-1H-imidazole |
1484.56 1014.35 766.67 696.64 |
C=C (Stretching) C-N (Stretching) C-Cl (Stretching) Ar-CH (Bending) |
|
2-(4-nitrophenyl)-4,5-diphenyl-1H-imidazole |
1596.28 1334.13 1245.22 1106.26 |
C=C (Stretching) N-O (Stretching) C-N (Stretching) C-C (Stretching) |
|
2-(4-methoxyphenyl)-4,5-diphenyl-1H-imidazole |
1609.91 1491.09 1242.66 1027.74 |
C=C (Stretching) C-H (Stretching) C-O (Stretching) C-N (Stretching) |
4.4. Antimycotic activity
Procedure
After incubation, the diameter of the inhibition zone was measured accurately using a calibrated ruler or digital caliper.
Figure 2 Zone of inhibition of synthesized compound against C. Albicans
Table No. 4
|
Name Of the Compounds |
C. Albicans (mm) |
Control (mm) |
|
2,4,5-Triphenyl-1H-imidazole |
16 |
22 |
|
2-(4-chlorophenyl)-4,5-diphenyl-1H-imidazole |
12 |
22 |
|
2-(4-nitrophenyl)-4,5-diphenyl-1H-imidazole |
10 |
22 |
|
2-(4-methoxyphenyl)-4,5-diphenyl-1H-imidazole |
15 |
22 |
CONCLUSION
REFRENCES






Ramanathan N.*, Nivetha B., Praveen Kumar K. C., Raghul Gandhi P., Ragul E., RajKumar N., Synthesis, Characterisation, Biological Evaluation and Analogizing the Antimycotic Activity of 2,4,5-Triphenylimidazole Derivatives, Int. J. of Pharm. Sci., 2025, Vol 3, Issue 3, 324-332. https://doi.org/10.5281/zenodo.14986869
 10.5281/zenodo.14986869
10.5281/zenodo.14986869